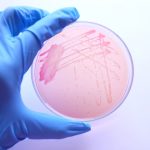

细菌生物膜:持久的公共卫生挑战
在美国和世界范围内,细菌性疾病是一个重大的公共卫生挑战,特别是那些与水和食物供应有关的传染病。虽然很多研究都集中在在环境中自由生活的细菌上,但对能够以生物膜形式形成固着群落的细菌的生态学了解较少。生物膜是位于活表面或惰性表面的紧密排列的细胞群落,它们被分泌的胞外多糖(复合糖)包围,本质上创造了一个微型的“微生物城市”。生活在生物膜群落中的细菌可以以自由生活的细菌(浮游细胞)所不能的方式相互作用和交流,例如通过传递生化信号和交换遗传信息。
Aliyar Fouladkhah教授及其在田纳西州立大学的研究小组旨在了解更多关于这些形成生物膜形成细菌的细菌。在这样做时,他们希望鼓励预防性方法,从而减少疾病导致的潜力或致病性,并且在能够引起感染之前在食品和水供应中的患病率。Fouladkhah教授的研究专注于使用新兴干预措施,如升高的静水压和新的菌丝和杀菌化合物的应用,以实现这一点,特别是靶向毒素毒素的生产大肠杆菌(一种大肠杆菌导致食源性疾病和潜在致命的肾脏并发症称为溶血性尿毒症综合征),非胸腺沙门氏菌塞洛瓦斯,公共健康 - 重要的刨床李斯特菌和致病物种Cronobacter。“Serovar”一词用于鉴定细菌内细菌的特定亚组。
细菌生物膜是一个显著的公共卫生挑战。他们的理解对预防与食物和水供应有关的传染病很重要
FOULADKHAH教授与国内和全球利益相关者密切合作,以全面的方法,以便传播其应用研究可交付成果,以确保微生物安全,监管合规性和经济可行性降低这些食物中的病原体。Prof Fouladkhah’s research group has provided extramurally funded education opportunities for undergraduate, Master’s and PhD students, post-doctoral and visiting scholar fellows and, in addition, has held public health workshops, training events, certification programmes, and consultations in the Dominican Republic, Guatemala, South Africa, and Haiti.
生物膜形成细菌病原体
自1854年伦敦伦敦宽阔的街道历史悠久的霍乱爆发以来,水供应的安全是公共卫生实践和基础设施的一个组成部分。Fouladkhah教授和他的团队调查了地表水中几种细菌的持续存在 -李斯特菌,滋阴毒素生产大肠杆菌和沙门氏菌塞洛瓦斯在5,25或37左右储存28天O.C.研究结果表明,这些微生物能够在低营养条件下生存,并强调需要采取措施防止食物和水源的最初污染。例如,农作物可能在收割前或收割后与地表水接触,在加工过程中产生潜在的污染。许多未加工的农产品不会经过消费者额外的“杀死步骤”来消灭微生物病原体,因此这些农作物的污染是传染疾病向消费者传播的重要途径。生物膜的形成也与作物病原体的转移和加强建立有关,为进一步了解产生生物膜的细菌以及防止其形成和增殖的方法提供了进一步的支持。
志贺毒素生物膜的形成与灭活大肠杆菌
在2009年至2017年期间,在美国的700多种录制的水性疾病爆发中,至少15次是由此引起的大肠杆菌和/或沙门氏菌。在同一时期,10,596集的疾病与感染有关大肠杆菌包括2000多起住院治疗和近4000起死亡。其他数据显示,在北美27个地点采集的未经处理地表水样本中,大约80%的样本含有人类病原体,例如大肠杆菌。
Fouladkhah教授认为,除了在水中持续存在28天之外,细菌的致病性可能仍然存在,这意味着它们在地表水中停留的时间越长,其危害性也不会显著降低。需要进一步的实验研究来研究毒力相关基因的表达大肠杆菌, 也
l . monocytogenes和沙门氏菌使用培养无关的方法,例如逆转录PCR或在体外致病性测定。术语毒力描述了病原体或微生物在宿主中感染或引起疾病的能力。
公共卫生微生物实验室的研究小组得出的结论表明,这些微生物能够长时间存活,即使是在低营养环境中,因此,首先需要防止食物和水源污染。所研究的细菌病原体也能够在非生物表面形成细菌生物膜,这进一步突出了预防方法的必要性,如最近实施的美国食品安全现代化法案。

压力胁迫,多毒性,易感沙门氏菌塞洛瓦斯
由于技术的进步,食品和制药行业越来越多地利用升高的静水压力,以防止患有病原生物的污染,并且具有潜力破坏食品的污染。静水压力升高(或PascAlisation)的过程包括将产品放置在密封包装中,然后将它们放入含水的气密钢室中。然后使用泵在该隔室内产生高压环境,同时确保温度变化可能影响食品的质量。大多数微生物无法在升高的压力下存活,从而确保产品的安全性。然而,在暴露于超高压后病原体发生的情况较少的证据,即设法生存的细菌会发生什么?
FOOLADKHAH教授的研究小组是第一个发布对这一主题的研究之一。他们比较了压力和野生型(正常)的能力沙门氏菌塞洛瓦斯生产生物膜。他的研究结果表明,两种形式的沙门氏菌都有类似的生物膜产生能力。这很重要,因为它会增加对压力的理解,例如压力,并不总是导致具有增加的致病性的抗性细菌,并且相同的预防策略将针对压力和野生型表型沙门氏菌型。此前进行的研究也表明,与浮游细胞相比,多药耐药和易感的沙门菌血清可形成对常见抗菌干预更耐药的细菌生物膜。
细菌病原体的生物膜和浮游细胞是气候敏感的传染病,其流行和增殖将在气候变化的景观下增强。
cr s茅饼干在婴儿护理环境中
C. Sakazakii.是一种可以在一系列年龄组中引起感染的细菌,但也许最大的威胁是其在干燥条件下持续存在的能力,例如婴儿配方公式,以及随后的早产或非常年轻的婴儿致命感染的风险。
FOOLADKHAH小组教授记录了许多历史性的全球爆发C. Sakazakii.以帮助理解这种病原体感染背后的流行病学。他还讨论了可采取的措施,以减少婴儿感染的风险,包括鼓励母乳喂养和按照监管和公共卫生机构的要求制备婴儿配方奶粉。除了直接措施外,还有一些措施可以在生产阶段实施,以防止婴儿产品受到这种机会致病菌的污染。
生产者需要意识到采样少量食品的局限性。由于所选样品可能没有显示污染,因此单独依靠采样和测试可以为产品的安全提供虚假的安全感。有许多方法可用于减少污染的可能性
C. Sakazakii.,例如基于压力或温度的干预和使用消毒剂,以防止生物膜形成在生产和制备区域的食物接触表面中。生产者而不是依靠测试方法,可以通过整体和预防性的食品安全管理系统,例如危险分析关键控制点和美国食品安全现代化法案所关节的那些。

控制生物膜的形成李斯特菌
李斯特菌在美国食品中死亡发作的前三个原因是少量食物中的病原体之一,可以在制冷条件下繁殖,使其对食品工业和公共卫生的主要威胁。此病原体的先前爆发对消费者安全产生了重大影响,并导致利益攸关方的经济损失。此外,l . monocytogenes可在其他不利条件下持续存在,如低pH值或高盐浓度。孕妇、幼儿、老年人和免疫功能低下的人更容易感染这种普遍存在的机会性病原体。
因此,需要开发有效和安全的方法来消除这种细菌。公共卫生微生物学实验室一直在做,使用轻度热量和乳腺(天然存在的抗生素)的组合表明协同方法会导致失活l . monocytogenes但是,在使用Nisin和升高的温度和压力的治疗时间增加之间存在紧密控制的权衡。
l . monocytogenes特别能够在各种生物和非生物表面上形成生物膜,使其在食品中的预防和消除令人生畏和复杂的任务。
细菌生物膜和食源性疾病
以前的研究审查了环境压力源的影响,例如温度,压力或pH的剧烈变化,可以对细菌具有巨大的变化。暴露于这种压力源可能导致细菌对它们变得更具抗性或可以提高细菌对特定压力源的敏感性。FOULADKHAH教授对使用新兴的技术,如升高的静水压力和使用新的菌株和杀菌化合物,用于在公共卫生关注的植物中群体的植物中的可持续性,微生物的有效和经济可行的方法和经济上可行的方法。
在最近的出版物中,FOOLADKHAH教授还说明,随着环境温度的增加,气候变化景观中的微生物食品安全和水性疾病将在气候变化景观中继续保持重要的公共卫生挑战,因为环境温度的增加可能在传染病的扩散和传播方面发挥着非常重要的作用。他解释说,极端天气事件可以促进从动物食品生产设施到地表水的微生物病原体的传播。在这些方式中,气候变化将是食物和水性感染的“威胁乘数”。有必要制定立法和基于证据的最佳实践,以确保未来几年食品和供水的安全性。
个人反应
您认为保证我们的食品和供水安全最有效的方法是什么?

